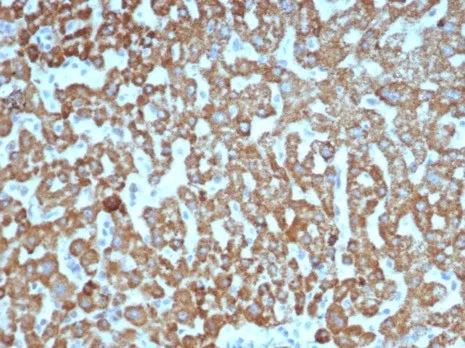

Formalin-fixed, paraffin-embedded human liver stained with VEGF Recombinant Rabbit Monoclonal Antibody (VEGFA/7635R). HIER: Tris/EDTA, pH9.0, 45min. 2°C: HRP-polymer, 30min. DAB, 5min.
This MAb recognizes proteins of 19-22kDa (reducing) and 38kDa-44kDa (non-reducing), identified as various isoforms of Vascular Endothelial Growth Factor or Vascular Permeability Factor (VEGF/VPF). It is highly specific to VEGF, which is a homodimeric, disulfide-linked glycoprotein with a close homology to platelet derived growth factor (PDGF). There are multiple isoforms of VEGF containing 206-, 189-, 165-, and 121-amino acid residues. The smaller two isoforms, VEGF165 and VEGF121, are secreted proteins and act as diffusible agents, whereas the larger two remain cell associated. VEGF/VPF plays an important role in angiogenesis, which promotes tumor progression and metastasis.
There are no reviews yet.